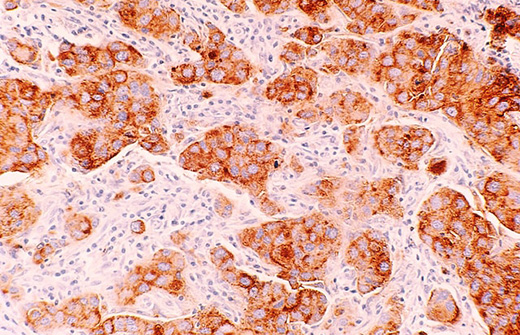

Трихомониаз // Источник: Unsplash
Трихомониаз представляет собой инфекционное заболевание, возбудителем которого является трихомонада.
Причины возникновения трихомониаза
Трихомониаз относится к венерическим инфекциям, так как передается при половом контакте. В крайне редких случаях возможен бытовой путь заражения – при использовании одной мочалки или полотенца с инфицированным человеком.
Симптомы трихомониаза
Инкубационный период, то есть время от момента инфицирования до появления первых признаков заболевания, составляет от 4 дней до 4 недель.
При трихомониазе женщины предъявляют жалобы на выделение пенистой жидкости из влагалища белесоватого цвета с неприятным запахом (его иногда сравнивают с ароматом протухшей рыбы). Может наблюдаться покраснение половых органов, выраженный зуд и жжение, усиливающиеся при интимной близости. При проникновении возбудителя в уретру развивается так же и ее воспаление, которое проявляется болью и жжением при мочеиспускании.
У большинства мужчин, инфицированных трихомонадами, заболевание протекает бессимптомно. В некоторых случаях мужчина предъявляет единственную жалобу – на боль и жжение во время мочеиспускания.
При отсутствии своевременного адекватного лечения трихомониаз может стать причиной развития бесплодия. И, если у женщин неприятная симптоматика заставляет обратиться к доктору, то у мужчин при бессимптомном течении трихомонады употребляют питательные вещества спермы, исподволь убивая детородную функцию.
Опасность данного заболевания еще и в том, что трихомонады могут стать местом жительства для других микроорганизмов, например, гонококков, возбудителей гонореи, и трепонемы, возбудителя сифилиса. Бактерии, находясь внутри трихомонады, недосягаемы для лекарственных препаратов. Поэтому, пока не пролечен трихомониаз, избавиться от некоторых других бактерий просто невозможно.
Диагностика трихомониаза
Диагностика трихомониаза основывается на микроскопическом исследование мазка из половых органов (у женщин -- выделения из влагалища, у мужчин -- выделения из мочеиспускательного канала и секрет предстательной железы). Так же информативны метод прямой иммунофлюоресценции, ПЦР или посев.
Что можете сделать вы
При появлении симптомов заболевания необходимо без промедления обратиться к доктору.
Что может сделать доктор
Доктор назначает специальные противотрихомонадные лекарства, средства для повышения защитных сил организма, витамины и физиотерапевтическое лечение. Важный момент – лечиться должны оба партнера одновременно, на время терапии очень важно отказаться от секса. После завершения лечения необходимо пройти контрольное обследование.
Профилактика трихомониаза
Исключение случайных половых связей, использование презерватива – вот основные способы профилактики трихомониаза. В качестве экстренной меры может быть рекомендовано использование антисептиков в течение двух часов после полового контакта.